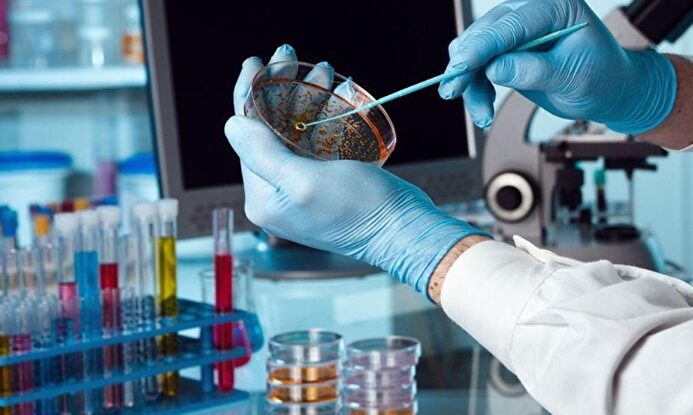
Las biotecnológicas europeas | LD

María Jesús Montero, en una imagen de archivo | EFE
María Jesús Montero, en una imagen de archivo | EFE
Los datos que demuestran que el problema fiscal de España está en el gasto y no en los impuestos
Diego Sánchez de la Cruz
La austeridad basada en recortar gasto es mucho más efectiva que la consistente en subir impuestos.